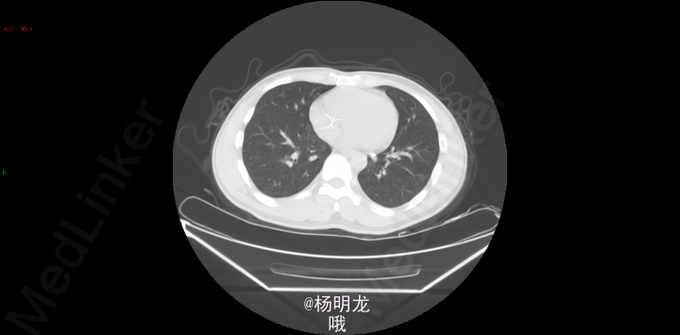

男,28岁; 结肠癌术后化疗后22个月,发现直肠癌可疑肺转移6个月,化疗10周期后; 直肠指诊:直肠距肛门4cm前壁可触及一菜花样肿物,表面不光滑,活动度可,退指指套染血。 CEA 6.15ng/ml 2013.6诊断为升结肠癌,外院行手术治疗,术后病理:溃疡型中分化腺癌,个别区域为粘液腺癌,伴神经内分泌分化,LNM 2/46,大网膜转移性癌。 术后奥沙利铂+依托泊苷+希罗达方案化疗10周期。
2014.9因大便带血,行肠镜检查,病理提示直肠癌。 2014-10-8胸部CT:双肺新出现多发微小结节,大者约0.2cm,高度警惕肺内转移。 遂于我院行FOLFIRI方案化疗,10周期。
术前诊断 直肠癌 升结肠癌术后 双肺多发结节 转移瘤? 名称:开腹直肠癌切除,结肠造口术(Hartmann术) 探查:右上腹粘连,肝脏只探及部分,质地略韧,未触及肿物。直肠肿物上端位于盆底腹膜返折处,侵及腹膜,与左侧精囊粘连紧密。肿瘤4x4x3cm。无腹水,右腹部原术区未触及异常。 由于盆腔狭窄、粘连,向深部游离骶前间隙时出现静脉出血,紧急压迫止血。通过压迫不再出血后,于肿瘤上缘15 cm切断乙状结肠,于肿瘤下缘3cm以闭合器闭合直肠并切断直肠,切除肿瘤和肠管。 发生骶前静脉大出血,估计有2000ml。输血红细胞4u,血浆4u。
“结肠癌术后,化疗后” (1)(直肠切除标本) 直肠中-低分化腺癌,部分呈微乳头结构,伴少许黏液分泌,局部伴坏死,可见脉管瘤栓及神经侵犯。肿瘤细胞退变,伴纤维组织增生,符合中度治疗后改变(TRG3级),肿瘤侵透肌层累及直肠旁脂肪及盆底腹膜及环周切缘。上切缘及下切缘均未见癌。 淋巴结转移性癌(5/32) 肠壁淋巴结 5/15 肠系膜淋巴结 0/17 ypTNM分期:ypT3N2a 病例特点: 1.青年男性,双原发大肠癌; 2.升结肠癌(pTxN1bM1) 3.直肠癌(ypT4N2aMx),脉管瘤栓、神经侵犯,环周切缘受累。